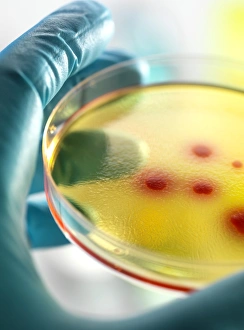

Agar Jelly Collection
Agar jelly: A crucial ingredient in the world of bacteria research 🔬
All Professionally Made to Order for Quick Shipping
Agar jelly: A crucial ingredient in the world of bacteria research 🔬. This gelatinous substance, derived from red algae, plays a pivotal role in cultivating and studying various bacteria strains, including F005 / 0845, F005 / 0846, and F005 / 0847. Agar jelly's unique properties allow for the creation of solid media, ensuring optimal growth conditions for bacteria, enabling scientists to explore their intricacies and advance our understanding of microbiology. #BacteriaResearch #Microbiology #Science #LabLife